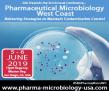

Artificial Intelligence Technology Solutions Announces Launch of SCOT 2.0
RENO, NV, April 16, 2019 (GLOBE NEWSWIRE) -- via NEWMEDIAWIRE – Artificial Intelligence Technology Solutions Inc. (AITX: OTCPK) is pleased to announce that Robotic Assistance Devices (RAD -www.roboticassistancedevices.com), its wholly owned subsidiary has …